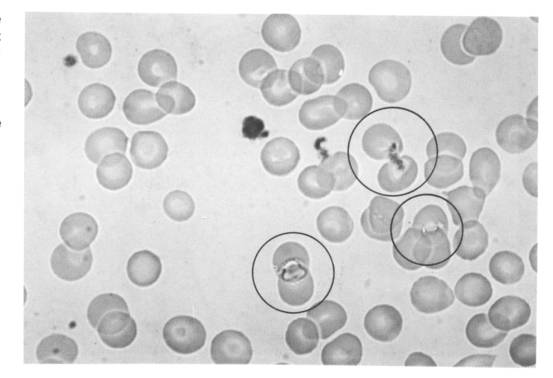

Mikroparasiten als Krebsauslöser
Inhaltsübersicht:
- Entstehung von Krankheiten durch Mikroorganismen
- Wie kommen Mikroparasiten in den Körper?
- Was machen Mikroparasiten in Blutzellen und Organen?
- An welchen Symptomen sind eingedrungene Erreger zu erkennen?
- Was unternimmt die Immunabwehr gegen die Eindringlinge?
- Wie pflanzen sich die eingedrungenen Erreger fort?
- Wie kann durch Mikroparasiten Krebs entstehen?
- Unterschiedliche Belastung befallener Zellen
- Krebs = das letzte von 4 Krankheitsstadien
- Dr. Webers Krebsdefinition
- Metastasierung
- Wieso sind Oozoiten und Merozoiten so extrem überlebensfähig?
- Mit welchen Mitteln können die Mikroparasiten ausgeschaltet werden?
- Bücher von Dr. A. Weber
Entstehung von Krankheiten durch Mikroorganismen Dr. Alfons Weber vertrat nach jahrzehntelanger Forschung den Standpunkt: "Die Krankheiten der leidenden Menschheit sind im wesentlichen Offenbarungen eines dauernden Kampfes, der oft schleichend und unerkannt zwischen den pathogenen Mikroorganismen und dem am höchsten entwickelten Organismus ausgetragen wird.
Ob es dabei zu einem kurzen, langen, symptomarmen oder symptomreichen Krankheitsgeschehen kommt, hängt im wesentlichen von der Zahl, Größe, Form, Chemie, Fermenteigenschaft, vom Stoffwechsel und Lebenszyklus der eingedrungenen Krankheitserreger sowie von den Abwehrmöglichkeiten des infizierten Organismus ab.
Daher ist es wichtig, zu wissen, wie solche Kleinstorganismen (Einzeller) in den Körper gelangen, was sie dort bewirken und wie sie sich vermehren.
Wie kommen Mikroparasiten in den Körper? Zunächst sollte man beachten, daß grundsätzlich eine unendliche Vielfalt von einzelligen und mehrzelligen Lebewesen in einem menschlichen Körper vorhanden sind und alle darin ein bestimmtes Mengenverhältnis aufweisen und irgendeine nützliche Aufgabe zu erfüllen haben.
Erst wenn massive Ungleichgewichte entstehen und von innen oder außen ein Zuviel von einer Art entsteht oder eindringt, beginnen wirkliche Gesundheitsprobleme. Wird ein Mensch (oder auch Tier) nun von bestimmten Kleinstlebewesen zu stark bevölkert, weist dies zunächst darauf hin, daß etwas aus dem Gleichgewicht geraten ist - sei es geistig, psychisch oder organisch, dass die Energie zur Abwehr nicht ausreicht oder Fremdeinflüsse einfach zu stark sind. Dann können durch das überhand nehmende Eindringen z.B. von Mikroparasiten verschiedenste Krankheiten entstehen - auch Krebs.
Dr. Alfons Weber hat nach jahrzehntelanger Forschung durch Mikroskopaufnahmen bewiesen, daß bei nahezu jeder Krankheit incl. Krebs bestimmte virengroße Einzeller (sog. Protozoen oder Plasmodien) in zu großer Anzahl in Blutzellen und in Organen eindringen, sich dort ernähren, vermehren und durch Stoffwechselgifte die befallenen Zellen erschöpfen, zur vorzeitigen Teilung veranlassen und sie zerstören können. Weil sie letztlich (Mit)Auslöser von Krebs sein können, benannte er sie 'Ca-Protozoen' oder 'Ca-Plasmodien' [mehr dazu s. Webers Parasitennachweise]
Dabei handelt es sich um eine Gruppe biologisch sehr nahe verwandter Protozoen - es gibt runde, ovale, sichelförmige, stabförmige, fadenförmige und amöbenartige CA-Protozoen - , die als belebte Ursache der Krebskrankheit anzusehen sind.
Der Lebenskreislauf der krebsverursachenden CA-Protozoen spielt sich vollständig im Blutgewebe ab, nämlich in den roten Blutkörperchen und im Blutplasma. Dabei gibt es virengroße Entwicklungsformen und riesengroße Erwachsenenformen - der Größenunterschied ist enorm.
Speziell bei Krebs benennt Dr. Weber als Infektionsquellen für die von ihm so genannten 'Ca-Plasmodien' u.a.
- Infektionen durch Mücken-, Bremsen- oder Zeckenstiche und andere stechenden Gliederfüßler, wenn sie bei der jeweils vorhergehenden Blutmahlzeit Plasmodien aufgenommen haben. Durch die Stiche gelangen die Plasmodien unter die Haut, entweder zunächst in die Lymphe und von dort ins Blut oder direkt ins Blut, wenn eine Blutkapillare getroffen wird. Es bilden sich Pusteln.
- Übertragung durch ‚plasmodien-infizierte Menschen’: durch die Plazenta kann eine Mutter die Erreger aufs Kind im Mutterleib übertragen, wenn ihr Blutplasma sehr stark infiziert ist
- durch Plasmodien verseuchte Blutkonserven: durch eine Transfusion von Fremdblut können ungezählte Ca-Protozoenstämme eingeschwemmt werden und der Empfänger der Blutkonserve dadurch entscheidend geschwächt werden.
- Impfungen mit protozoär infektiösem Material
- den ‚infizierten Hund’
- das ‚infizierte Rind’: durch rohes Rinderblut oder –serum sowie durch rohes Rindfleisch (Die Bibel warnt vor allem, was aus Tierblut zur Ernährung hergestellt wird, also z.B. Blutwurst, rohes Steak etc. Daher sollen alle Tiere beim Schlachten völlig ausbluten!)
Die Schwere des Primärinfektes hängt vom Alter, der Abwehrlage, der Zahl der eingedrungenen Krankheitserreger und noch weiteren Faktoren ab.
[Tipp: Wenn nach Insektenstichen die Haut möglichst bald oder auch täglich vorbeugend mit Mohnblütenöl oder noch effektiver mit Kampfer-Lichtöl eingerieben wird, vernichtet dies gleich die meisten oder gar alle eingebrachten Mikroparasiten, mindert den Juckreiz, reduziert oder verhindert Entzündungen und nimmt die Schwellung!]
Was machen Mikroparasiten in Blutzellen und Organen? Blut hat logistische Aufgaben im Dienste des Organismus inne. Seine Abwehrfunktionen sind relativ gering. Das rote Blutkörperchen (Erythrozyt) ist wegen seiner verschiedenen spezifischen Aufgaben die wehrloseste Zelle des gesamten Organismus! Das macht sie zum leichten Opfer für Mikroparasiten.
Die virengroßen einzelligen Protozoen (Plasmodien) besitzen die Fähigkeit, sich mit ihrem Mund an den Zellwänden festzusaugen, durch Enzyme die Zellwand durchlässig zu machen und dann in sie einzudringen. Sie vermehren sich bevorzugt in Blutzellen (z.B. den roten Blutkörperchen, den sog. Erythrozyten). Blut ist daher in der Regel aufgrund der vielen eingedrungenen Plasmodien hochinfektiös! (Bibel: "Im Blut ist der Tod!")
Der Organismus versucht, den Verlust an roten Blutkörperchen lange Zeit auszugleichen; eine wirklich erfolgreiche Immunreaktion gegenüber den eingedrungenen Parasiten ist das im Grunde nicht. Daher können sich die Parasiten ständig vermehren.
Die eingedrungenen Erreger verdauen während ihrer Jugendphase (Trophozoiten) den gesamten roten Blutfarbstoff (Hämoglobin) der Wirtszelle. Das tun sie, bis die Zelle leergefressen ist und sie inzwischen geschlechtsreif geworden sind (Gametozyten).
Als ständige Schmarotzer im Blut ernähren sie sich überdies wie ihre menschliche Wirtszelle von den dort befindlichen Kohlehydrat-, Eiweiß- und Fettmolekülen, um sich dadurch am Leben zu erhalten und zu vermehren. Insofern entziehen sie der eroberten Wirtszelle als Konkurrenten lebensnotwendige Nahrungsbestandteile und schwächen sie dadurch.
Die Erreger produzieren arteigene Stoffe (Toxine, Fermente, u.a.). Die von den Parasiten eingesetzten Giftstoffe können die Zellwand und das Innere der roten Blutkörperchen restlos verdauen. Sie können bis in den Kern der Gewebszelle vordringen, den sie restlos zerstören.
Durch ihre Ausscheidungsprodukte vergiften sie die Zellen. Insofern schwächen und schädigen sie die Wirtszellen oder können sie zerstören. Das Parasitenwachstum, ihre Zellteilung, Zellatmung und Fermentbildung ist letztlich für die Wirtszelle bzw. den gesamten Wirtsorganismus lebensbedrohlich.
Sie können eigenständig die befallenen Zellen oder die Blutbahn verlassen und in Stammzellengewebe eindringen, wo sie zur Zellgewebsneubildung, -wucherung und -zerstörung sorgen.
Die Fermentwaffen der Erreger bewirken anfangs ein ungerichtetes, vermehrtes Zellwachstum und letztlich den Untergang wichtiger, funktionaler Zellfunktionen, Zellen und Organen.
Dr. Weber meinte, daß die von ihm entdeckten Protozoen insgesamt eine größere krankmachende Wirkung zeitigen, als Bakterien und Pilze zusammengenommen.
Nach seinen bisherigen Lebendbeobachtungen zu urteilen, zerstören die nicht-amöboiden Endoparasiten in erster Linie das erythrozytäre, die amöboiden Ca-Protozoen das thrombo- und erythrozytäre Blutgewebe.
s. auch Übereinstimmende Eigenschaften aller Krebs erregenden Protozoen
An welchen Symptomen sind eingedrungene Erreger zu erkennen? Aus der Lymphe oder dem Blut dringen die Mikroparasiten bis an die Gelenke, Muskeln, Nerven und Organe vor und rufen Symptome hervor. [Mehr dazu]
Die Organstörungen sehen bei allen Erregerarten in etwa gleich aus: Zum Beispiel tauchen anfangs immer Drüsenschwellungen, Austritt seröser Flüssigkeit nach außen und nach innen (Exantheme, Enantheme, Exzeme) auf, ob es sich nun um Tuberkel-, Typhus-, Milzbrandbazillen, Borreliose- oder Luesspirochäten oder um Pneumokokken handelt.
Wie pflanzen sich die eingedrungenen Erreger fort? Die einzelligen Erreger pflanzen sich geschlechtlich oder ungeschlechtlich fort:
Wenn sich 2 reife Gametozyten paaren, entstehen aus der runden, durchsichtigen Mutterzelle (Oozyste) oder auch durch ungeschlechtliche Vermehrung (Merozoiten) Myriaden von Jungformen (sog. Oozoiten, flaggellenbewehrte, nur virengroße Mikroformen). Sie sind sehr klein, aber sehr widerstandsfähig und sichern ihren Bestand auch unter widrigsten Umständen.
Protozoenarten vermehren sich in Notfällen - unter medikamentöser Einwirkung, bei Kälteschocks oder Hitzesterilisierungsmaßnahmen oder vor allem beim Ableben des Wirtes - extrem schnell auf ungeschlechtliche Weise (durch Aufteilung genetischen Materials in viele kleinste Einheiten = Merozoitenbildung als biologisches Überlebensprogramm ). So überlebt die genetische Information über lange Zeiträume und unter widrigsten Lebensbedingungen. Diese hypobiotische (scheinbar unbelebte) Übergangsphase kann unter Umständen Monate bis Jahre überdauern, bis ein mit Merozoiten (die meist als Viren angesehen werden) versetzter infektiöser Staub lange nach dem Ableben des Wirtsorganismus in die Lunge oder den Intestinaltrakt eines neuen Wirtsorganismus gerät und es in diesem zu einer erneuten Vermehrung der Protozoenart kommt.
Sie schwärmen aus und docken an noch unbewohnten roten Blutkörperchen an, saugen sich mit ihrem Mund an der Zellwand an, bohren sich mit den ihnen zur Verfügung stehenden Enzymwaffen hinein.

Aus dem Farbatlas „Pathogene Protozoen“: „Stadien der Oogenese beim runden Ca-Protozoon (Figur 4)“ und „Entwicklungsstadien des befruchteten Säugetiers“ Darin fressen sie sich dick und rund (die Jugendformen werden Trophozoiten genannt). Die Erwachsenenformen (Gametozyten) sind im roten Blutkörperchen oder schauen bereits aus dem roten Blutkörperchen heraus und bewegen sich mit der Zelle durch eine Art Fuß fort. Sie ziehen ihre eroberte Wirtszelle schneckenartig hinter sich her. Sie können sich, ohne ihre Wirtszelle zu verlassen, an einem nahe gelegenen Erythrozyten anheften, und diesen zu sich heran ziehen. Manchmal schwimmen die Gametozyten frei im Blutplasma herum, wo sich die weibliche mit der männlichen Gametozytenform paart und ein neuer Entwicklungszyklus beginnt.

Blutausstrich: Zellmund, Zellafter und das vom Riesenprotozoon ausgeschiedene, eisenhaltige, dunkle Zellexkrement sind deutlich zu erkennen; es besteht eine morphologische Ähnlichkeit mit dem Erreger „Pneumocystis carinii“. Es kommt auch vor, daß Gametozyten von ihrer jeweils eroberten Zelle aus - ohne sie verlassen zu müssen - miteinander paaren, so daß mehrere rote Blutkörperchen wie verschweißt erscheinen und klumpig den Blutfluß hemmen
Aus dem Farbatlas „Pathogene Protozoen“ Tafel Nr. 237: „Der zum größten Teil noch im Ery-Vehikel liegende Donator führt in den ebenfalls noch von Ery-Haut umgebenen Rezeptor das milchig aussehende genetische Material.
Dr. Weber konnte fotografieren, daß es außer dem eben beschriebenen geschlechtlichen Vermehrungszyklus noch eine ungeschlechtliche Vermehrung gibt (sog. Merozoitenbildung) Dabei schnürt eine längliche filamentöse Plasmodienform unter physiologischem Stress (z.B. Medikamenteneinwirkung) kleine, rundliche Überlebensformen von sich ab, sorgt somit für die Vervielfachung und Erhaltung des eigenen genetischen Materials bei Bedrohung. Diese Überlebensstrategie wird höchst erfolgreich von fast allen Mikroorganismen praktiziert (ungeschlechtlicher Vermehrungszyklus).
Aus dem dreisprachigen Farbatlas "Pathogene Protozoen im Blut-, Organ-, und Tumorgewebe" (1970):
Phase 1: Reife Oozyste, Ausschwärmende Oozoiten (ca. 19 Uhr)
Phase 2: Einbohren des Oozoiten in rotes Blutkörperchen (ca. 21 Uhr)
Phase 3: Im roten Blutkörperchen Heranwachsender Trophozoit (12 Uhr)
Phase 4: Konjugation männl. und weibl. Gametozytenform (ca. 14 Uhr)
Phase 5, 6, 7: Entwickungsstadien (Protoplasmastrahlung, Blastula-, Morulastadium) (15-18 Uhr)
Warum vernichten die Immunabwehrzellen die Eindringlinge nicht? Die in eine Blutzelle eingedrungenen Mikroparasiten verstecken sich lange in den roten Blutkörperchen und können sich so ihrer Bekämpfung und Einschließung durch die weißen Blutkörperchen entziehen. Bei fortgeschrittener Infektion bilden sie regelrechte Trutzburgen aus absterbenden Erythrozytenhaufen, in die kein Leukozyt mehr hineinkann.
Ein heranwachsender Trophozoit ist für die mobilen Abwehrzellen im Blutplasma (Lymphozyten und Leukozyten) unerreichbar, denn die Abwehrzellen sind nicht imstande, ein rotes Blutkörperchen zusammen mit den darin enthaltenen Parasiten zu fressen. Auch die immunbiologische Abwehr ist dem gegenüber machtlos.
Ist die Immunaktivität im Blutplasma noch recht hoch, wagen sich die jungen Erwachsenenformen (Gametozyten) nicht aus der eroberten und sie schützenden Wirtszelle heraus, paaren und vermehren sich vorwiegend innerhalb der roten Blutkörperchen. Wenn aber die Anzahl Leukozyten anzahlmäßig unterlegen und überfordert ist, paaren sich die Erwachsenenformen (Gametozyten) auch außerhalb der roten Blutkörperchen und docken an junge, noch unbesetzte rote Blutkörperchen an.
Wenn man das Blutplasma, die ernährende Umwelt der Mikroparasiten z.B. mit Mitteln gegen Malaria überschwemmt, reagieren herumschwimmende Parasiten sofort darauf, indem sie in rote Blutkörperchen eindringen und dort vor dem chemischen Angriff Schutz suchen. Die sich ständig vermehrenden Erreger erobern das Blutplasma, das ernährende Bindegewebe und schließlich die unterschiedlichen Stammzellenverbände.
Was unternimmt die Immunabwehr gegen die Eindringlinge? Die weißen Blutkörperchen (Leukozyten) im Blutplasma bemühen sich, die eingedrungenen Plasmodien zu fressen (sie sich einverleiben, zu phagozytieren, um sie durch Fermente aufzulösen).

Aus dem Buch „Haben wir potentielle Krebserreger schon im Blut?“ (1983): „Natürliches Lebendblutpräparat eines Leukämiekranken. Drei mobile Abwehrzellen (Leukozyten), in deren Zelleib überwiegend undurchsichtige, membranbegrenzte Verdauungsvakuolen gespeichert sind. In der linken Bildhälfte liegen vier ausgestoßene Verdauungsvakuolen.
Wegen der Menge von Eindringlingen und letztlich einem Mangel an Fermentwaffen gelingt es ihnen nicht, die Eindringlinge ganz zu zerstören. Stattdessen füllen sie sich mit Erregern an, die sie in speziellen Bläschen einschließen (gefangen nehmen, vakuolisieren) oder einfach nur in ihrem Zellplasma festhalten. Diese Abwehrbemühungen schwächen aber die Leukozyten entscheidend. Sterben sie, werden die darin eingeschlossenen gefährlichen Erreger erneut freigesetzt.
Sie pflanzen sich über Jahrzehnte in den roten Blutkörperchen und im Blutplasma des befallenen Menschen fort. Ihre Fermentwaffen (Lysosome) lösen die Blutgefäßwände auf. Die Infektion setzt sich in das Bindegewebe und das Organparenchym des Wirtsorganimus fort.
Die Stammzellen des jeweiligen Organgewebes reagieren auf die Infektion zunächst durch Einschließen (Gefangennahme in der Zelle, Vakuolisierung) der Erreger und später durch überstürzte Zellteilung (Mitose, die zu Wucherungen führt).
Sobald der Nachschub an Nährstoffen versiegt, kehrt sich die Wucherung (Hyperplasie) in ein Zellsterben (Hypoplasie und Aplasie) um, wobei die vormals gefangenen Parasiten wieder freikommen.
Vielfältige Auswirkungen und Symptome der Protozoeninfektionen Je nachdem in welchem Organbereich die Infektion stattfindet und wie stark sie ist, entstehen Symptome, die mit Pusteln (Exanthemen), Einsickern (Infiltrationen) seröser Flüssigkeit ins Gewebe (Enanthemen), Verfall funktionaler Zellkolonien, Bildung minderwertigen Reparaturgewebes (Narben) und Hohlraumbildung einhergehen.
Die Folgen reichen von leichter, kompensierbarer Funktionseinschränkung bis zu tödlichem Kompensationsversagen. Dr. Weber beschreibt differenziert, wie sich Symptome bilden und auswirken.
Bevor eine Krebserkrankung diagnostiziert werden kann, gibt es mehrere Folgen einer Protozoeninfektion.
Während einerseits die Energie und die Funktionfähigkeiten der befallenen Zellen bzw. Organe stetig abnehmen, nehmen die Zahl und die krankmachenden Eigenschaften der eingedrungenen Einzeller stetig zu.
Wie kann durch Mikroparasiten Krebs entstehen? Aufgrund o.a. Beweise definiert Dr. Weber: "Krebs ist - wie jede andere Seuche auch! - eine Infektionskrankheit, die von unterschiedlichen belebten Krankheitserregern (Plasmodienarten, Einzellern bzw. einzelligen Urtierchen, Mikroparasiten) hervorgerufen wird.
Die in allen Krebsarten gefundenen Mikroparasiten gehören zur Gattung der Plasmodien. Dr. Weber nennt sie CA-Plasmodien (d.h. Karzinomplasmodien).
Seit Weber’s Forschungen und Wirken wissen wir, daß die Krebskrankheit keine lokale, sondern eine generelle Infektionskrankheit mit bestimmten sich im Blutorgan bevorzugt aufhaltenden, den Wirt nicht wechselnden Mikroparasiten plasmodialer Natur sind.
Dr. Webers Krebsdefinition Krebs ( = die Krebsgeschwulst) ist (...) ein finales, durch starke Zellgewebsneubildung, Zellgewebswucherung und Zellgewebszerstörung gekennzeichnetes Krankheitsmerkmal einer bestehenden Allgemeininfektion. Diese exakt nachweisbare Allgemeininfektion, die durch einen auffallend chronischen und sehr langsamen fortschreitenden Verlauf gekennzeichnet ist, (...) wird durch krankmachende tierische Mikroparasiten (Kleinstparasiten, sog. Protozoen) verursacht.“ (Dr. A. Weber: "Haben wir potentielle Krebserreger schon im Blut?", 1983, S. 7-8.
Krebs = das letzte von 4 Krankheitsstadien Die Krebsgeschwulst ist das letzte von vier Krankheitsstadien:
Eine Geschwulst kann nur in Stammzellenverbänden entstehen, die an sich eine enorme Vermehrungsfähigkeit besitzen.
- Es beginnt mit der versteckten, zunächst kompensierten Plasmodieninfektion im Blut
- geht über die nicht mehr kompensierte Infektion im Blut (intravasal, dekompensiert),
- zur kompensierten Infektion im Organgewebe (extravasal kompensiert),
- schließlich dekompensierten Infektion im Organgewebe (extravasal dekompensiert).
Die aussichtslose Abwehr im Blutplasma, an dem hauptsächlich die weißen Blutkörperchen (Leukozyten) und die Blutplättchen (Thrombozyten) beteiligt sind, läuft viele Jahre unbemerkt ab, weil die starken Verluste an roten und weißen Blutkörperchen sowie Blutplättchen lange durch die enorme Vermehrungspotenz der an der Blutbildung beteiligten (hämatopoetischen) Stammzellengewebe vollständig kompensiert werden können.
Bei Krebspatienten ist der prozentuale Anteil befallener roter Blutkörperchen immens hoch... Die eingedrungenen Erreger belasten die Stammzellenverbände bis zur völligen Erschöpfung und deren Untergang. Das Phänomen der Zellwucherungen stellt dabei nur eine Übergangsphase dar, das nur solange statt findet, als noch ausreichend Energie und Wachstumsressourcen vorhanden sind.
In eine Stammzelle kann sich ein Oozoit niemals hineinbohren, wie es bei den roten Blutkörperchen der Fall ist. Vielmehr werden die Oozoiten von den Stammzellen gefressen (phagozytiert), um sie aus dem lebenswichtigen Extrazellularraum weg zu räumen. Solange die Stammzelle noch intakt und mit Abwehrfermenten reich ausgestattet ist, wird der eingeschlossene (phagozytierte) Oozoit in einer sog. Verdauungsvakuole eingeschlossen und auf diese Weise neutralisiert. Die Fermentwaffen des Oozoiten können dabei nicht zu Wirkung kommen, sein Stoffwechsel ist abgewürgt, so daß er in den Zustand der Hypobiose (minimaler Lebenszustand) gerät, der für die Stammzelle ungefährlich ist. Aber mit der vorläufigen Ausschaltung eines einzigen Mikroparasiten durch Phagozytose und Vakuolisierung ist es nicht getan; es kommt eine Unzahl von Mikroparasiten an die Stammzelle heran und mit jedem Neutralisierungsvorgang werden die Abwehrfermente der Stammzelle, ihre Fähigkeit zu phagozytieren und Vakuolen zu bilden geringer. Die Stammzelle ist also zu Beginn dieses Geschehens zwar infiziert, aber in ihren Funktionen noch nicht wesentlich eingeschränkt. Und solange die Zellzwischenwege um sie herum noch mit Oozoiten verstopft sind, widmet sie sich vorwiegend den Aufräumarbeiten; erst wenn diese frei sind, widmet sie sich wieder ihren eigentlichen Aufgaben - der Bildung von Endzellen - d.h. sie wird wieder vermehrungs- und differenzierungsaktiv. Insofern verbrauchen die Mikroparasiten Energie, Stoffe und Zeit der Stammzellen, was sie schwächt und von ihrer eigentlichen Aufgabe abhält.
Eine Stammzelle kann im Gegensatz zu Leukozyten, die sich eigenständig auf einen Erreger zu bewegen können, nur jene Oozoiten einfangen, die in ihre unmittelbare Nähe kommen. Dazu setzt sie einen besonderen Zellplasmafortsatz ein (Mikrovillus), der sich gezielt auf den wahrgenommenen Mikroparasiten hin ausdehnt, ihn „verhaftet“ und dann in die Stammzelle gebunden einschleust.
Bei 20 bis 25 phagozytierten und vakuolisierten Mero- und Oozoiten ist noch kein Anzeichen einer Funktionsschwäche bei der Zelle zu erkennen; aber sobald die Anzahl eingeschleuster Erreger diese Anzahl übersteigt, fängt die Zelle an zu schwächeln. Sie hört aber nicht auf, fortgesetzt nach Oozoiten in den Zellzwischenwegen zu suchen - es ist wie eine Sucht - und allmählich können die Erreger nicht mehr vollständig oder gar nicht mehr vakuolisiert werden und bewegen sich frei im Zellplasma herum. Dies ist dadurch bedingt, daß die Stammzelle mit Nährstoffen und Sauerstoff unzureichend versorgt ist; auch stehen kaum noch Fermentwaffen zur Verfügung. Nun können die frei im Zellplasma befindlichen Mikroparasiten ihre Virulenz voll entfalten: Erregerspezifische Gifte (Exotoxine) beschleunigen zunächst aus Abwehrgründen die Stoffwechselvorgänge in der Zelle und wichtigen Zellfunktionen. Später drosseln sie sie jedoch. Die Anzahl eingeschlossener, gefangener Mikroparasiten und die zunehmend schlechtere Ernährungslage der betroffenen Zelle entscheiden also darüber, ab wann dieses Kampfgeschehen zu allgemeiner Funktionsunfähigkeit der Zellvorgänge umschlägt.
Bei einer leichten Infektion sind die wenigen gefressenen Mikroparasiten alle innerhalb von undurchsichtigen Verdauungsvakuolen gefangen... Nimmt die Infektion zu, sind dann einige und später sehr viele Erreger in durchsichtigen Vakuolen oder frei im Zellplasma und entfalten dort ungehemmt ihre Virulenzeigenschaften.
Je mehr Erreger ungehemmt in der Zelle wüten, desto schneller geht sie unter. Dabei dauen die Erreger mit ihren proteolytischen Fermentwaffen die Wände des reichverzweigten Kanälchensystem der Zelle an und verursachen schwere Veränderungen am Zelleib, Zellkern und im Chromosomensatz. Diese Schädigungen in der Zelle beginnen aber schon in der vitalen Phase, wo die Zelle, während sie den Parasiten verdaut, von giftigen Stoffen des Parasiten (Exotoxine), getroffen wird. Durch diesen Reiz in der Frühphase der protozoären Infektion kommt es zu beschleunigten Zellteilungen und -differenzierungen - d.h. zur Entstehung einer Geschwulst...
Unterschiedliche Belastung befallener Zellen Der Infektionsgrad der einzelnen Zellen ist sehr unterschiedlich, je nach dem ob wenige (z.B. 2, 4, 8) oder viele Erreger (z.B. 40, 50, 80) eingeschleust wurden. Folglich ist auch die intrazelluläre mikroparasitäre Giftstoffdosis unterschiedlich hoch.
Oft sind die Erreger zahlenmäßig gegenüber den zirkulierenden Blutzellen und Blutplättchen um ein Vielfaches in der Überhand, wobei die kleinsten mikroparasitären Überlebensformen davon ca. 90 Prozent ausmachen.
In fast jedem weißen Blutkörperchen und Blutplättchen können überlebende Mikroparasiten entdeckt werden. In den weißen Blutkörperchen befinden sich im latent infizierten Blut bis zu ca. 40 Mikroparasiten, die jeweils in einer Verdauungsvakuole gefangen sind.
Im virulenten, tödlichen Stadium beträgt das Verhältnis solch infizierter Abwehrzellen bis zu 20 Prozent und in ihren Zellen sind dann an die 100 Mikroparasiten zum Teil vakuolisiert und zum Teil frei im Zellplasma schwimmend vorzufinden.
Es sind vor allem die frei gebliebenen Mikroparasiten, die der Abwehrzelle zum Verhängnis werden. Bei den zahlenmäßig stärker vorhandenen, aber viel kleineren Blutplättchen sind bei der tödlich infizierten Zelle bis zu acht Mikroparasiten vorzufinden.
Aus obigen Gründen kommt es zur verwirrenden Vielfalt von krankhaften Veränderungen, die krebskranke Zellen in ihrem Zelleib, Zellkern und Chromosomensatz aufweisen. Daher kommt auch die Vielgestaltigkeit krebskranker Zellen: Bei jedem Krebsgeschwür und jeder Leukämie gibt es gleichzeitig ungehemmte Zellwucherungen und Zellzerstörungen.
Metastasierung Im letzten Stadium der Krebskrankheit, wenn die Blut- und Lymphgefäße aufgelöst, das ernährende Bindegewebe überwunden und die Stammzellenkolonien infiziert sind (sog. viertes neoplastisches Stadium), kommt es zu wiederholten Verschleppungen von Stammzellenkolonien und damit auch von darin enthaltenen Krebserregern. Auf dem Blut- oder Lymphwege transportierte Tumorzellen-Verbände können in jedes Organ gelangen, vorzugsweise aber in die Lunge, Leber oder Niere, weil sie am stärksten durchblutet sind.
Eine Einnistung kann nur dann statt finden, wenn das Gewebe, auf das die metastasierende Zellkolonie auftrifft, selbst abwehrschwach und mit Erregern bereits verseucht ist (3. Stadium). Bei starker Abwehrlage werden die frisch eingetroffenen Tumorzellen nämlich phagozytiert und unschädlich gemacht. Aber die Situation ist in der Regel an vielen Stellen des Organismus eher schlecht, so daß die Wahrscheinlichkeit einer Einnistung organfremder, infizierter Zellen hoch ist.
Die auffallend ungleichmäßige Verteilung von Metastasen erklärt sich dadurch, daß die Abwehrlage stark variiert. Nur wenn sich die ankommende Tumorzelle mittels Zellplasmafortsätzen (Mikrovillii) anhaften kann, bei gut erhaltener Teilungsfähigkeit und nicht zuletzt der Fähigkeit, Nahrungsstoffe aus dem extrazellulären Raum für sich zu beanspruchen, kann eine Tochtergeschwulst entstehen.
Dr. Weber hat in den Tochtergeschwülsten stets diesselben Ca-Protozoenstämme wie in der Muttergeschwulst nachgewiesen. Auch der Infektionsgrad ist in beiden Geschwulstarten gleich hoch.
Die Mikroparasiten treiben durch Sauerstoff- und Nährstoffentzug, die Zerstörung des Blutorgans, Verstopfung der Stammzellen-Zwischenzellwege und proteolytische Abwehrfermente die befallenen Zellen zu unkoordinierten Hochleistungen an und führen letztlich das tödliche Ende des Wirtsorganismus herbei. Die Erreger existieren aber auch in abgestorbenem Gewebe weiter.
Wieso sind Oozoiten und Merozoiten so extrem überlebensfähig? Die virusgroßen, einzelligen Oozoiten und Merozoiten sind gegen hohe Temperaturen, große Kälte, ultraviolette und ionisierende Strahlen, gegen Desinfektionsmittel und Antibiotika ebenso resistent wie gegenüber Austrocknung; die Erreger überleben nicht nur im toten Krebsgewebe sondern auch in Blutproben, die viele Monate lang unter sterilen Bedingungen gelagert werden. Und wenn das Venenblut eines Krebskranken bei hoher mittlerer Temperatur (+56 Grad = Brutschranktemperatur) 6 Stunden lang „bebrütet“ wird, kommt es zu einer enormen Vermehrung der Mikroparasiten durch ungeschlechtliche Vermehrung.
Ebenso verhält es sich mit krebsigem Gewebe, das mechanisch zerkleinert und in steriler Ringerlösung verdünnt wird. Wenn man das präparierte Venenblut nach der Bebrütung in einem Wasserbad kocht, gehen zwar die Wirtszellen unter, die Parasiten aber überleben.
Wird mikroparasitär infiziertes Blut bei einer Temperatur von 160 bis 180 Grad Celsius in einem Sterilisator erhitzt, so überleben viele dieser Erreger die Sterilisationszeit: Es können durch eine einstündige Hitzeeinwirkung von 160 Grad Celsius nicht alle Mikroparasiten abgetötet werden.
Bemerkenswert ist auch die enorme Widerstandskraft der CA-Plasmodien gegenüber ultravioletten und radioaktiven Strahlen: Auch nach 60 Minuten Ultraviolett-Bestrahlung sind diese zum größten Teil noch lebendig. Diese Resistenz ist zum Teil darin begründet, daß das zerfallende und einschmelzende Eiweiß des Wirtsgewebes die Mikroparasiten wie ein Mantel umgibt und gegen lebensfeindliche Umweltfaktoren schützt.
Positiv stimmende therapeutische Konsequenzen dieser Erkenntnisse Es sind nach Dr. Webers Beweisen mikroparasitäre Einzeller, die Krebs und viele andere Krankheiten erzeugen - also keinesfalls 'entartete, böse Zellen' oder die vielen Umweltgifte. Folglich sind Operation, Chemotherapie und Bestrahlung nicht erforderlich.
Stattdessen sollte dafür gesorgt werden, daß auf jeden Fall der Energiestatus der Zellen (Zellspannung) bzw. des ganzen Organismus erhöht wird (was auch bedeutet, daß man energieraubende Einflüsse reduzieren muß!), andererseits sollten die einzelligen Mikroparasiten gezielt bekämpft werden. Beides kann relativ sicher, in wenigen Monaten, sehr preiswert und notfalls in Eigenregie vorgenommen werden, sofern kein kompetenter Arzt oder Heilpraktiker für alternative Behandlungsmethode zu finden ist.
Vorzugsweise sollten diejenigen therapeutischen Maßnahmen bedacht werden, die die Ausbreitung des identifizierten Erregers eindämmen und gleichzeitig die Vitalität des Wirtsorganismus anheben. [Genau diese Anforderungen erfüllen die Kampfermilchpulver von innen und Kampfer-Lichtöl von außen. Die Lichtglobuli sorgen ergänzend zum Kampfer-Lichtöl durch die lange Besonnungszeit vor allem für die Vitalisierung!]
Dabei ist es wichtig, die plasmodiale Infektion frühzeitig, d.h. dann, wenn die Infektion sich noch auf das Blutorgan beschränkt (erstes Stadium) oder spätestens dann, wenn die Infektion jenseits der Blutbahn noch kompensiert wird (zweites Stadium), behandelt wird. Dann sind nämlich die hämatopoetischen Stammzellengewebe und die Abwehr der Organe noch einigermaßen intakt und funktionstüchtig. Eine Behandlung im dritten Stadium, nämlich dann, wenn das nährende Bindegewebe bereits angegeriffen, oder im vierten Stadium, wenn die Basalmembranen durchbrochen und die Erreger in Stammzellenkolonien eingedrungen sind, sieht schweren oder kaum überwindbaren Hindernissen entgegen.
Dabei ist zu bedenken, daß die immunbiologische Abwehr des Organismus - z.B. durch ungelöste biol. Konfliktschocks - versagt hat; daß die mikroparasitären Überlebens- und Verbreitungsformen eine ungeheure Resistenz haben, denn sie haben eine äußerst widerstandsfähige Kapsel, die von jeglichen Abwehrzellen weder angedaut noch verdaut werden können; die einzig verbleibende, relative Unschädlichmachung ist die Vakuolisierung (Einschließung, Umhüllung) dieser Kleinstformen.
Hingegen sind die erwachsenen Ca-Protozoenformen (Gametozoiten) sehr wohl durch antiplasmodiale Maßnahmen eindämmbar. Hier ist die therapeutische Chance gegeben, die die regelmäßige Einnahme von Antimalariamitteln (z.B. MMS) oder die Blutelektrifizierung (oder Bio-Lichtkonzentrate, vor allem Kampfermilchpulver) bieten: Die Differenzierung der in roten Blutkörperchen schmarotzenden Jugendformen (Trophozoiten) zu Erwachsenenformen (Gametozoiten) kann aufgrund der antiinfektiven Wirkung nicht mehr erfolgen. Damit ist die Produktion von weiteren Überlebens- und Verbreitungsformen (Oozoiten und Merozoiten) gestoppt.
Wenn die biol. Konfliktschocks erkannt und gelöst worden sind und dann evtl. zusätzlich noch die gesamte Mikroparasitenpopulation des wehrlosen Blutorgans monatelang behandelt wurde, besteht die nachhaltigste Aussicht auf Erfolg. Gerade die Blutelektrifizierung und Lichtglobuli- und Kampfer-Lichtöl-Anwendung ist im Gegensatz zu chemischen Antimalariamitteln darauf ausgelegt, monatelang bedenkenlos angewendet zu werden. Dabei werden neben der antiinfektiven Wirkung die elektronegativen Abstoßungskräfte der roten und weißen Blutkörperchen sowie der Blutplättchen erhöht und damit deren Fließeigenschaften im Blutplasma verbessert; die Vitalität und Agilität der im Blutplasma befindlichen Endzellen verbessert sich erheblich. [Kampfermilchpulver von innen und Kampfer-Lichtöl von außen, sowie die elektroenergetische Aufladung der Lichtglobuli zeigt vergleichbare Effekte! - nebenwirkungsfrei auch bei längerer Anwendung]
Mit welchen Mitteln können die Mikroparasiten ausgeschaltet werden? Weber: "Die Zahl der Endoparasiten ist viel größer als von mir anfangs angenommen wurde... Ich habe Ca-Protozoen gefunden, die nicht (nur) zur Species der Sporozoa gehören, sondern Mastigophora, Ciliophora und Sarcodina sind... es ist damit zu rechnen, daß die Zahl der pathogenen Protozoen so groß ist wie die der Kokken und Stäbchen... Alle Protozoen aber sind Endoparasiten, die das befallene Blut- und Organgewebe schädigen und zerstören wie die erstbeschriebenen, runden, ovalen und sichel- und stabförmigen Ca-Protozoen."
Daher sind bei der Therpaie auch Mischinfektionen und Protozoendauerformen zu berücksichtigen.
Sowohl zur Vorbeugung gegen das Überhandnehmen von einzelligen Mikroparasiten in den Blutzellen und daraus entstehenden Energiemangel und systemischen Krankheiten - z.B. Krebs - als auch zur Behandlung bereits eingetretener Erkrankungen haben sich folgende Mittel einzeln - bzw. effektiver in Kombination - bisher bewährt:
Zur gezielten Mikroparasitenbekämpfung:
- Antimalariamittel (die Dr. A. Weber therapeutisch anwandte): Chininderivate (Chloroquin, Resochin oder Atebrin), anfangs hochdosiert, danach regeldosiert langfristig eingenommen (3 bis 4 Monate) erwiesen sich als vielversprechend. MMS dürfte besser und nebenwirkungsfreier sein!
- Blutelektrifizierung (nach. Dr. Robert C. Beck) mittels Beck-Blutzapper (Dunkelfeld-mikroskopisch konnte nachgewiesen werden, daß die Beck’sche Blutelektrifizierung eine dem Resochin ähnliche oder gar optimalere Wirkung hat.
- Kolloidales Silber (Silberwasser)
- Magnetpulser
- Kampfermilchpulver
- Kampfer-Lichtöl
Zur Anhebung der Zellspannung, des gesamten Energieniveaus und Unterstützung bei der Giftausleitung:
Dazu sind allgemeine Maßnahmen zur Stärkung des Immunsystems wichtig, um Rückfälle zu vermeiden und einige Umstellungen in Ernährung und Lebensführung wichtig.
Bei sehr knappem Finanzbudget (Kassen zahlen für o.g. Maßnahmen nichts...) reichen auch die preiswert selbst herstellbaren oder käuflichen Kampfermilchpulver, Kampfer-Lichtöl bzw. Mohnblütenöl und Lichtglobuli (s. Fallbericht bei Brustkrebs)
Sofern noch die preiswert erhältlichen Geräte für die Selbstherstellung von kolloidalem Silber (Silberwasser) und ozonisiertem Wasser erworben werden, sind mit ca. 200-400 Anschaffungskosten alle Kosten einer monatelangen (Selbst)Behandlung erfasst...
Durch jede dieser o.g. Maßnahmen bzw. besser durch ihre Kombination werden im Verlaufe weniger Tage die Zellspannung auf normales Niveau (50-70 mV) erhöht. Im Verlaufe weniger Monate können die befallenen Blutzellen von den eingedrungenen Mikroparasiten befreit werden.
Dr. Weber: "Die laufende Beobachtung der Endoparasiten während der Behandlung ermöglicht ein objektives Urteil darüber, ob wir als Therapeuten ein wirksames Antiprotozoenmittel oder ein Placebo verabfolgt haben und ob die am kranken Organismus auftretenden Reaktionen nützlich (d.h. durch Protozoenleichen hervorgerufen) oder schädlich (d.h.von „Antiprotozoenmitteln“ verursacht) sind.
Bücher von Dr. A. Weber
- Über die Ursache der Krebskrankheit“ (1969)
- „Haben wir potentielle Krebserreger schon im Blut?“; 1983)
- „Jahrhundertskandal Krebs“ (1987, bis zum Jahr 2003 zurückgehalten)
- Dreisprachiger Farbatlas „Pathogene Protozoen im Blut-, Organ- und Tumorgewebe“ (1970)
- „Krebsbankrott“ (2003) von Ernst Wollenberg und Thomas Blasig
Home | Gesundheit | Krankheit | Zurück zum Thema
